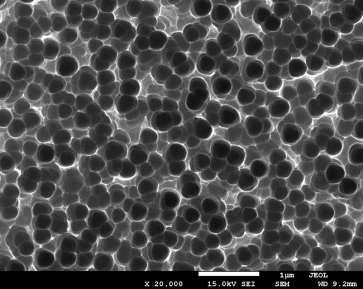
02

日前,中科院微電子研究所在多晶黑硅太陽能電池研究方面獲得重要突破。
黑硅是一種低反射率的硅材料,和常規的硅材料相比,它具有超強的吸收光線的能力,可用于太陽能電池產業。微電子所微電子設備研究室(八室)夏洋研究員帶領的研究團隊原創性地提出利用等離子體浸沒離子注入技術制備黑硅材料。該團隊利用自行研制的等離子體浸沒離子注入機(國家自然科學基金委、中科院裝備項目、方向性項目支持)制備了多種微觀結構的黑硅材料,在可見光波段黑硅的平均反射率為0.5%,與飛秒激光制備黑硅的反射率相當。同時該工藝適應大批量制備,成本低,生產效率高。
相關科研論文發表在Solar Energy、Energy Procedia、Journal of Electron Spectroscopy and Related Phenomena、《物理學報》等期刊上,已申請專利30余項。
通過對黑硅結構進行優化,并且對生產線電池配套工藝進行改進,在全國產設備生產線研發出多晶黑硅太陽能電池(156mm×156mm,多晶),批量平均效率高達17.46%,最高可到17.65%。

低反射的多晶黑硅 高效率多晶黑硅太陽電池
黑硅表面微觀結構,表面大量的納米孔可以增加光吸收

批量多晶黑硅電池實驗數據